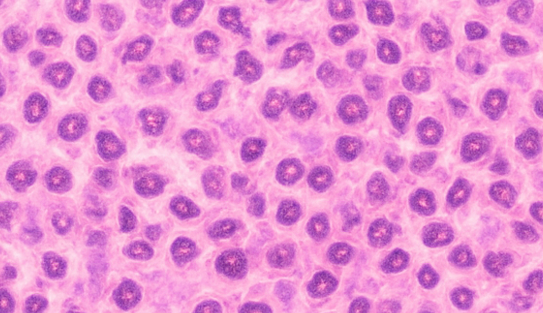
H&E.png

In histopathology, routine hematoxylin and eosin (H&E) staining, IHC (Immunohistochemistry), and ISH (In-Situ Hybridization) are the three most common detection methods. They help doctors and researchers observe tissue structure, protein expression, and genetic information at different levels. Below, we explain their meanings, applications, and relationships.
Routine Hematoxylin and Eosin (H&E) Staining
This is the most basic and commonly used tissue staining method. Hematoxylin stains the cell nucleus blue, and eosin stains the cytoplasm pink.
Function: Makes tissue structure clearly visible, like taking a "high-resolution color photograph" of the tissue.
Application:All surgical pathology specimens undergo H&E.
IHC (Immunohistochemistry)
IHC uses antibodies to recognize specific proteins and makes the "target protein" visible under a microscope through staining.
Functions: Determining tumor type, origin, prognosis, and biomarker expression.
Applications: Cancer diagnosis, scientific research experiments, and drug development.

ISH (In Situ Hybridization)
ISH is a technique for detecting at the gene level. It uses probes to identify RNA or DNA, causing specific genes to "globble" or become colored in tissues.
Functions:Detecting gene mutations, gene amplification, and viral infections.
Applications:HER2 gene amplification detection, HPV testing, and virus research.

The Connections And Differences Among The Three
Technique | Main Observation Level | Detection Content | Typical Applications |
H&E | Tissue structure | Cell morphology and structure | Basic pathological diagnosis |
IHC | Protein level | Protein expression location and intensity | Tumor classification, marker detection |
ISH | Gene level | DNA/RNA expression | Gene amplification, virus detection |
Connection: These three methods are often used together to form a complete diagnostic chain of "morphology + protein + gene."
Differences: They operate at different levels, but all rely on high-quality microscope slides.
Conclusion
The "Detective Journey" of a Slide
A hospital received a lung mass specimen from a patient.
Step 1: The doctor performed H&E staining and found it resembled adenocarcinoma, but was not entirely certain.
Step 2: IHC was performed—TTF-1 positive, p40 negative, further confirming it as lung adenocarcinoma.
Step 3: ISH was performed to check for EGFR gene mutations, providing a basis for precision medicine.
From structure → protein → gene, a single cell microscope slide holds the complete story from pathological diagnosis to targeted therapy.
Routine H&E, IHC, and ISH are three irreplaceable pillars of modern pathological diagnosis.
They work together to help doctors "see from the macroscopic to the microscopic," ensuring accurate diagnosis and more precise treatment.
Why are high-quality microscope slides?
Whether it's H&E, IHC, or ISH, all experiments must be performed on reliable microscope slides and cell microscope slides.
High-quality slides possess the following characteristics:
● High-transparency glass
● Low autofluorescence
● Strong adhesion (tissue does not detach)
● Smooth, flawless surface
● Suitable for automated staining instruments
These directly impact experimental quality and diagnostic results.
As a professional slide manufacturer, we offer a range of products including super white microscope slides, adhesion slides, and color-frosted slides, providing stable and reliable support for every step of your experiments.
Post time:2025-11-26



